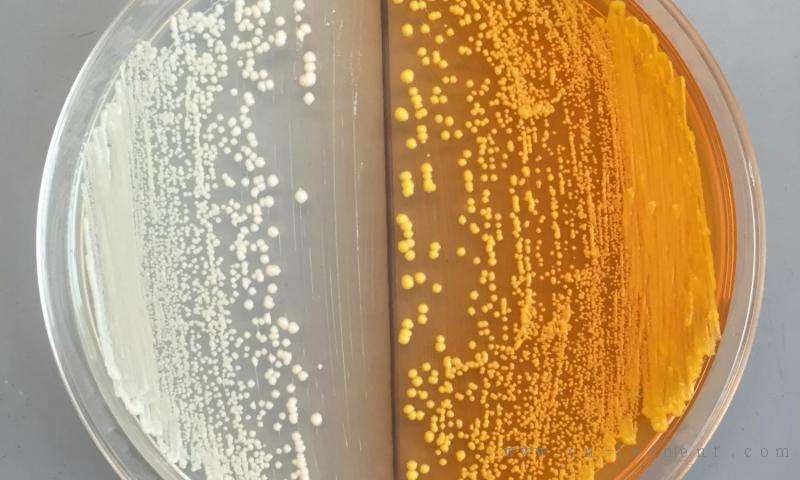

家有酿酒厂的家酿啤酒爱好者已经知道如何使用酵母将糖转化为酒精。但由加州大学伯克利分校的生物工程学家所率领的研究小组,已进一步完成了关键步骤,通过把需糖酵母转换成一个微生物工厂,来生产吗啡和其他可能的药物,包括抗生素和抗肿瘤治疗的药物。
在过去的十年中,少数合成生物学实验室一直致力于将微生物中一个复杂的,15步的化学通路复制到罂粟植物中,以使其能生产治疗药物。研究团队已经各自独立地使用大肠杆菌或酵母重建了罂粟中毒品通路的不同部分,但直到现在仍然缺失的是,能使一个有机体单独地执行从开始到结束任务的最终步骤。
5月18日,周一,提前出版在自然化学生物学(Nature Chemical Biology)杂志在线版的一项新研究中,加州大学伯克利分校生物工程学家John Dueber与魁北克康考迪亚大学的微生物学家Vincent Martin 通过在酵母工程菌中复制通路中的早期步骤,克服了这个障碍。他们能够合成网脉碱,它是罂粟中的的一种化合物,来自酪氨酸,是葡萄糖的一个衍生物。
“你从发酵的视角真正能做的是用葡萄糖来喂养酵母,因它是一种廉价的糖源,并有酵母需要的所有下游的化学步骤来合成目标治疗药物,”这项研究的首席研究员和生物工程副教授Dueber说。“通过我们的研究,所有的步骤都进行了描述,它们是彼此联系并被扩大的过程。这是一个不小的挑战,但它是可行的。”
打通从植物到微生物的道路
罂粟植物通路如此具有挑战性的性质使它能成为研究的有吸引力的目标。虽然它很复杂,但它也是研究人员建立新治疗方法的基础。异喹啉类生物碱,或BIAs,是在罂粟中发现的一类高生物活性的化合物,其家族包括了大约2500个从植物中分离出来的分子。
也许在BIA通路中最著名的就是阿片类药物,如可待因,吗啡和蒂巴因,它们是羟考酮和氢可酮的前体。但不同的路径将会导致产生解痉罂粟碱或抗生素前体二氢血根碱。
“植物有缓慢的生长周期,所以很难通过基因工程罂粟充分发掘所有可能由BIA通路合成的化合物,”研究的第一作者,加州大学伯克利分校生物工程系的博士生William DeLoache说。“把BIA通路转移到微生物中可极大地减少药物开发的成本。我们可以很容易地操控和调整酵母的DNA并快速测试出结果。”
研究人员发现,通过再利用甜菜中用于天然合成其活性颜料的一种酶,他们可以使酵母将酪氨酸——一种易于从葡萄糖衍生的氨基酸转变成多巴胺。
在康考迪亚大学Vincent Martin的实验室的帮助下,研究人员能够重建酵母中从酪氨酸到网麦碱的完整的七酶路径。
“能够到达网麦碱是很关键的,因为从网麦碱中产生可待因和吗啡的分子步骤在酵母中已经被阐述,”微生物基因组学和工程学教授Martin说。“此外,网麦碱是BIA通路的一个分子枢纽。从这里,我们可以探索多种不同的路径来合成其他潜在的药物,而不仅仅只是阿片类。”
监管机构的任务
这项研究的作者指出,该发现大大加快了家庭药物合成变为现实的时间点,不过他们呼吁监管机构和执法人员要多加注意。
“我们设想在一到两年的时间里,而不是十年或更长的时间,需糖酵母就能可靠地生产受控物质,”Dueber说。“现在是时候考虑解决这方面的研究政策,该领域的发展出奇的快,我们需要走在前面,以减少滥用的可能性。”
与该研究同时出版的自然(Nature)杂志上的一篇评论中,政策分析家呼吁这一新技术迫切需要监管。他们强调这项工作的许多好处,但同时他们也指出,“能够获得酵母菌株并具有发酵基本技能的个人都能利用自制的试剂盒来培养酵母。”
他们建议限制工程酵母菌的发放许可,授权研究人员指出,否则将会难以检测和控制工程酵母菌株的非法运输。
虽然这种控制可以起到帮助作用,Dueber说,“另外一个值得关注的是,一旦如何创建阿片类生产菌株的知识出现,任何接受过基本分子生物学知识的人理论上都可以利用它。”
另外一个监管目标将是合成和出售DNA序列的公司。“与病原微生物如天花相联系的序列限制已出台,”DeLoache说。“但是,也许是时候让我们期待能合成受控物质的序列了。”











































